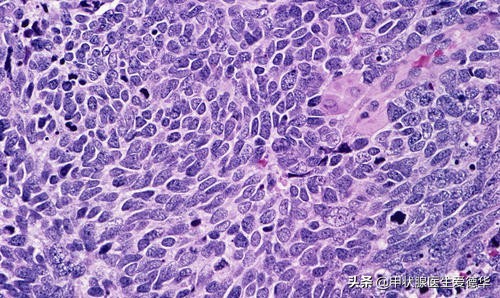
保守治疗好还是做化疗好,甲状腺髓样癌不治疗能活多久

小伙伴们大家好,今天爱德华也是如约而至。上一期(甲状腺髓样癌,你给我站住,你的狐狸尾巴(降钙素)露出来了)给大家介绍了甲状腺髓样癌的诊断方法。这一期呢,话题稍微有点沉重,我们来讲一讲甲状腺髓样癌应该如何治疗。
相信通过上一期的学习,小伙伴们对甲状腺髓样癌的难治性已经有了一定的了解,那么对于这样一种恶性程度相对较高的癌症,到底应该怎么治疗呢?要不要搏一把来接受手术呢?手术之后复发概率高不高呢?不要慌,且听爱德华慢慢讲解。
其实啊,甲状腺髓样癌虽然恶性程度相对较高,但是和癌症家族里一些出了名的恶棍(如:小细胞肺癌)比起来,它还是欠了点火候,所以甲状腺髓样癌的预后并没有如传闻中那般可怕,治疗方式也相对单纯。主要有——手术、靶向抗癌药治疗。
小细胞肺癌,癌症里出了名的“恶棍”,看着就让人头皮发麻
首先我们来看看手术,无论任何种类的癌症,手术都是它们的一大克星。要了解甲状腺髓样癌应该如何手术,首先我们要来了解一下甲状腺髓样癌的TNM分期。
在肿瘤学起步初期,人们对于一个肿瘤进展到了何种程度,没有明确的认识,只是根据经验,对其发展程度进行粗浅的划分,也就是大家经常听到的“早期”、“中期”和“晚期”。后来,就有人提出了一种分期方法,能够详尽细致地对肿瘤的进展程度进行划分,这便是TNM分期系统。

瘦骨嶙峋的“晚期”癌症患者,其实“晚期”是一种非常笼统的分期方法
其中“T”是是肿瘤一词英文“Tumor”的首字母,指肿瘤原发灶的情况,随着肿瘤体积的增加和邻近组织受侵犯范围的增加,依次用T1~T4来表示;
“N”是淋巴结一词英文“Node”的首字母,指附近区域淋巴结受侵犯或转移的情况。淋巴结未受累时,用N0表示。随着淋巴结受累程度和范围的增加,依次用N1~N3表示;
“M”是转移一词英文“metastasis”的首字母,指远处转移(通常是血道转移),没有远处转移者用M0表示,有远处转移者用M1表示。通过T、N、M三个维度情况综合判断,便能够对于肿瘤的进展情况,有一个清楚的认识。

甲状腺髓样癌的TNM分期
那么再回到甲状腺髓样癌上来,对于甲状腺髓样癌而言,“T4期以下且N0、M0”状态的患者,可以进行甲状腺全切术+颈部中央区淋巴结清扫术;对于“T4期或N0以上,且M0”状态的患者应该进行甲状腺全切术+颈部中央区淋巴结清扫术+单侧或双侧颈部侧区淋巴结清扫术。记不清手术方式的小伙伴们,需要复习一下往期的功课喽~(切,还是不切?甲状腺乳头状癌该选择何种治疗方式?)
而对于已经严重远处转移的患者(即M1期的患者),因为手术的治疗效果已经不甚理想,故而一般不建议再做手术了。仅在肿瘤过大,影响呼吸和吞咽时,切除一部分肿瘤组织,以缓解呼吸或吞咽困难的症状,而不再谋求完整的、根治性的切除。
那么对于已经不建议手术的患者,我们该怎么办呢?难道就不管不问了吗?肯定是不能的,这个时候,就要采取另一种治疗方式,也就是大名鼎鼎的——靶向抗癌药治疗。

hope”——对于大多数严重癌症患者来说,靶向抗癌药就是他们的希望
“靶向抗癌药”这个词大家可能有些陌生,但是如果提起一个电影,大家应该都有印象,那就是前一段时间爆火的——《我不是药神》。影片中提到的“格列宁”相信大家都还记忆犹新,“格列宁”的原型“格列卫”就是一种靶向抗癌药。

我们医务工作者不是药神,但是我们在向着药神迈进
甲状腺髓样癌使用的靶向抗癌药物有“凡德他尼”、“卡博替尼”等。根据临床试验的结果,这些药物能够有效使癌灶直径缩小,延缓甲状腺髓样癌的进展,改善患者的生存期和生活质量,可谓新一代的抗癌神器。
但是,就像《我不是药神》中演的一样,这些药物非常非常昂贵,往往短期使用,便已掏空家底。所以甲状腺髓样癌的治疗,还有很长的路要走,更多新的、便宜的治疗方式有待于被研发。

靶向抗癌药物——凡德他尼
那么到此,爱德华已经将甲状腺髓样癌的治疗方式讲解完毕。这期的话题略微有些沉重,但是没办法,疾病就是这样——轻松是偶尔的,沉重是一直的。但是希望大家不要被沉重的气氛所击倒,毕竟还有我们这么一群医生,在不断地和病魔抗争。
下集预告:下一篇,爱德华将给小伙伴们讲解甲状腺癌家族的最后一名成员,也是甲状腺癌中的终极BOSS——甲状腺未分化癌。
①*今条头日**,每周发布各类医学知识科普文章,欢迎关注。
②作者为前甲状腺外科医生,临床医学硕士。如果有小伙伴想要咨询个人病情(备注:仅限于甲状腺疾病),可私信联系。
③小伙伴们想了解甲状腺疾病的哪些领域,都可以评论留言,我会酌情考虑介绍相应的知识。